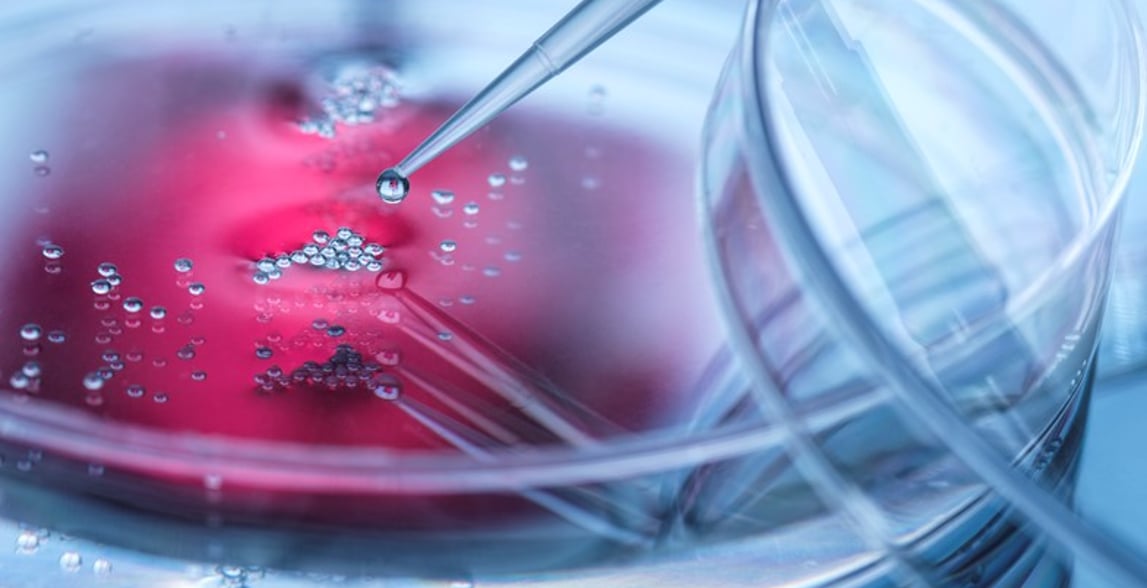

Throughout modern human history, there have been periods of great technological innovations that have radically disrupted and changed the ways in which societies and economies work. From the steam engine to electricity to computing, these incredible inventions which were the hallmarks of the previous industrial revolutions have completely transformed our lives over the past two centuries. We believe that another revolution is underway – this time in relation to biology. If the previous industrial revolutions were about inventing new things to make our lives better, then the biological revolution is about pushing our understanding of biology and unpacking millions of years of evolution, the insights from which will transform healthcare and redefine our health and wellbeing.
The facts of life
For millennia, much of biology has remained a black box. The complexity, sophistication, and intricacy of the human body has prevented us from making significant inroads into reducing the number of deaths from cancers, heart diseases, Alzheimer’s and so on. Cardiovascular disease remains the number one killer globally, claiming approximately 18 million lives per year. One in two people in the UK will develop cancer over their lifetime. And if we are lucky enough to live beyond 80 years, one in six of us in the UK will develop dementia.
These are grim statistics, but our hope is that the figures will dramatically reduce as the biological revolution unfolds, and we will return to specific examples of companies radically improving the outcomes in these areas later in the paper. Before exploring where a biological revolution could lead, it is helpful first to understand where it has come from.
The study of life
The biological revolution has been in the making for a long time. Biology in Greek means “the study of life”, and this subject has always been at the centre of human interests. However, there have been many false premises and setbacks along the way.
An example is Pythagoras’ theory of ‘spermism’. His hypothesis was that babies were created purely from male sperms, which circulated around the male body to gather instructions about making different body parts. From there the sperms were nurtured and matured in the woman’s womb. The problem with this theory, as Aristotle identified two centuries later, was that the sperms couldn’t possibly produce female babies simply because men don’t have female parts. Looking back, such theories might sound absurd, but it is hard to blame the thinkers when they lacked the proper tools and technologies we now have to study life.
Things began to change with the invention of the microscope. For the first time, we were able to see the components of life and other microorganisms which we didn’t know existed. This led to a burst of new knowledge, the ‘Cambrian explosion’ moment of biology. As the technologies have improved over time, it is now possible to observe the cellular machinery, how different proteins interact with each other, leading to a much better understanding of biology and how to manipulate it.
The code of life
One of the most important technologies in life sciences, the one that propelled our knowledge of biology to a new height, is gene sequencing. Gene sequencing allows us to read the code of life. It’s fascinating that despite the complexity of biology, the code of life is written with just 4 DNA letters – A, T, C and G. Hidden behind what seems to be the chaos and unpredictable emergent properties of biology is in fact a rather orderly information system. There is great potential to turn the anarchy of biology into an information science. By using experimental observations, machine learning, gene editing and other advanced techniques, we can start mapping out the genetic circuits within a cell and understand how different genes relate to each other at the tissue level, organ level, and eventually for the whole organism.
Over the past 20 years, the cost of sequencing a whole human genome has declined dramatically from over $100m to under $1000 today. If Illumina has led the charge in bringing down the costs of sequencing, then younger companies, such as 10X Genomics, have been striving to increase the resolution of sequencing. Now we can sequence at the individual cell level, and compare the genomes of healthy cells versus diseased cells to figure out what genes are responsible for the disease. Using single cell sequencing, we can also start to build a map of cell-to-cell interaction. Imagine for a moment, if we were to master human biology and learn to configure it like we would a computer. If a part goes awry, we know exactly what’s wrong and how to fix it. Developing a drug to treat a disease could be as simple as writing a new software to fix a computer virus.

The bright side of life
Whereas we normally associate revolutions with a big and transformative change, sometimes they are generated by the accumulation of gradual changes, imperceptible at the time. We believe that the life science industry is building momentum for a transformational change in the same spirit, with the biological revolution having been quietly gathering pace over the past decades.
During 2020, we witnessed this radical shift first-hand. The reason we could develop the vaccine against Covid-19 so rapidly was due to the accumulation of lots of tiny changes that have taken place across many different industries over the past few decades. These include material science, chemistry, biology, genomics and data science. On its own, each improvement would have been insufficient to move the dial, but in combination, it allowed companies to create effective vaccines at an unprecedented speed. Let’s explore a few other examples where we see the potential for transformational change in healthcare.
Cardiovascular (Verve Therapeutics)
Cardiovascular diseases are diseases of the heart and blood vessels, with lifestyle being a major risk factor. What if we could mitigate the risks of suffering from heart diseases regardless of lifestyle? Or better still prevent heart diseases altogether?
Verve Therapeutics hopes to find out. It is developing a single-course gene-editing medicine to lower the risk of cardiovascular diseases. The company’s technology is based on advances in several areas.
First, large population genomic studies have revealed new insight that there are certain genetic variants that confer natural protection against cardiovascular diseases for some people. By manipulating the genes we’ve discovered that can lower or raise cholesterol, it is possible to provide a natural protection for those who are less fortunate.
Second, ground-breaking gene editing tools, so-called base editing technology, enable us to manipulate genes precisely and efficiently.
And finally, biotech companies have made a lot of progress on how we deliver gene editing tools and other medicines to cells. Packaged within a lipid nanoparticle, mRNA (as used in some Covid-19 vaccines) codes the production of a gene editing tool: human cells have literally become the manufacturers of the gene-editing tool that then goes and modifies the targeted cells within their own body.
In isolation, each of these advances might not solve the enormous problem of cardiovascular diseases. However, when combined, they offer a step change in the way we can prevent and treat these diseases.
Alzheimer’s (Denali Therapeutics)
Advances in many different sciences have enabled Denali Therapeutics to develop new approaches to the treatment of neurodegenerative diseases. One of the longstanding challenges in addressing neurodegenerative diseases has been our inability to find a way to deliver large molecular drugs through the blood brain barrier (BBB). While the BBB helpfully stops harmful substances getting into the brain, it also unhelpfully prevents many drugs getting into the brain and therefore limits our abilities to treat and prevent Alzheimer’s and other conditions.
Denali is making great progress in addressing this challenge and the company has already demonstrated its ability to get complex molecules into the brain. In addition to unlocking access to the brain, Denali is also leveraging on advances in genetics, pathology and cell biology to identify pathways that trigger neurodegeneration. This brings us closer to establishing what the underlying causes of diseases are and therefore increasing the chances of developing effective drugs.
Cancer (Illumina/Grail)
Unfortunately, despite many decades of cancer research, the disease remains the second largest killer in the world. If we were able to diagnose cancer at an early stage, it could substantially improve the outcomes for patients and provide an opportunity to turn cancer into a chronic disease, rather than a killer.
Grail is one of the leaders in the early diagnosis of cancer. The company provides a test, based on a single blood draw, that can diagnose dozens of cancers in their early stages. This test can be performed in the doctor’s office, possibly annually as part of the general health check-up for seniors.
Grail’s achievement so far is already nothing short of transformational. What many have failed to appreciate is how powerful different technologies can be when they are brought together, leading to even more radical change than the sum of parts. In Grail’s case it has combined breakthroughs in genome sequencing and AI to great effect.
A new phase of life
While we have only highlighted a few disease areas, it is important to note that the biological revolution is impacting the entire spectrum of health. As investors in transformational health companies, we are excited about identifying and supporting innovative companies through the biological revolution.
Risk Factors and Important Information
The views expressed in this communication are those of Rose Nguyen and Julia Angeles and should not be considered as advice or a recommendation to buy, sell or hold a particular investment. They reflect personal opinion and should not be taken as statements of fact nor should any reliance be placed on them when making investment decisions.
This communication was produced and approved in November 2021 and has not been updated subsequently. It represents views held at the time of writing and may not reflect current thinking.
Stock Examples
Any stock examples and images used in this communication are not intended to represent recommendations to buy or sell, neither is it implied that they will prove profitable in the future. It is not known whether they will feature in any future portfolio produced by us. Any individual examples will represent only a small part of the overall portfolio and are inserted purely to help illustrate our investment style.
This communication contains information on investments which does not constitute independent research. Accordingly, it is not subject to the protections afforded to independent research, but is classified as advertising under Art 68 of the Financial Services Act (‘FinSA’) and Baillie Gifford and its staff may have dealt in the investments concerned.
All information is sourced from Baillie Gifford & Co and is current unless otherwise stated.
The images used in this communication are for illustrative purposes only.
Baillie Gifford & Co and Baillie Gifford & Co Limited are authorised and regulated by the Financial Conduct Authority (FCA). Baillie Gifford & Co Limited is an Authorised Corporate Director of OEICs.
Baillie Gifford Overseas Limited provides investment management and advisory services to non-UK Professional/Institutional clients only. Baillie Gifford Overseas Limited is wholly owned by Baillie Gifford & Co. Baillie Gifford & Co and Baillie Gifford Overseas Limited are authorised and regulated by the FCA in the UK.
Persons resident or domiciled outside the UK should consult with their professional advisers as to whether they require any governmental or other consents in order to enable them to invest, and with their tax advisers for advice relevant to their own particular circumstances.
Financial Intermediaries
This communication is suitable for use of financial intermediaries. Financial intermediaries are solely responsible for any further distribution and Baillie Gifford takes no responsibility for the reliance on this document by any other person who did not receive this document directly from Baillie Gifford.
Europe
Baillie Gifford Investment Management (Europe) Limited provides investment management and advisory services to European (excluding UK) clients. It was incorporated in Ireland in May 2018 and is authorised by the Central Bank of Ireland. Through its MiFID passport, it has established Baillie Gifford Investment Management (Europe) Limited (Frankfurt Branch) to market its investment management and advisory services and distribute Baillie Gifford Worldwide Funds plc in Germany. Similarly, it has established Baillie Gifford Investment Management (Europe) Limited (Amsterdam Branch) to market its investment management and advisory services and distribute Baillie Gifford Worldwide Funds plc in The Netherlands. Baillie Gifford Investment Management (Europe) Limited also has a representative office in Zurich, Switzerland pursuant to Art. 58 of the Federal Act on Financial Institutions ("FinIA"). It does not constitute a branch and therefore does not have authority to commit Baillie Gifford Investment Management (Europe) Limited. It is the intention to ask for the authorisation by the Swiss Financial Market Supervisory Authority (FINMA) to maintain this representative office of a foreign asset manager of collective assets in Switzerland pursuant to the applicable transitional provisions of FinIA. Baillie Gifford Investment Management (Europe) Limited is a wholly owned subsidiary of Baillie Gifford Overseas Limited, which is wholly owned by Baillie Gifford & Co.
China
Baillie Gifford Investment Management (Shanghai) Limited 柏基投资管理(上海)有限公司(‘BGIMS’) is wholly owned by Baillie Gifford Overseas Limited and may provide investment research to the Baillie Gifford Group pursuant to applicable laws. BGIMS is incorporated in Shanghai in the People’s Republic of China (‘PRC’) as a wholly foreign-owned limited liability company with a unified social credit code of 91310000MA1FL6KQ30. BGIMS is a registered Private Fund Manager with the Asset Management Association of China (‘AMAC’) and manages private security investment fund in the PRC, with a registration code of P1071226.
Baillie Gifford Overseas Investment Fund Management (Shanghai) Limited
柏基海外投资基金管理(上海)有限公司(‘BGQS’) is a wholly owned subsidiary of BGIMS incorporated in Shanghai as a limited liability company with its unified social credit code of 91310000MA1FL7JFXQ. BGQS is a registered Private Fund Manager with AMAC with a registration code of P1071708. BGQS has been approved by Shanghai Municipal Financial Regulatory Bureau for the Qualified Domestic Limited Partners (QDLP) Pilot Program, under which it may raise funds from PRC investors for making overseas investments.
Hong Kong
Baillie Gifford Asia (Hong Kong) Limited 柏基亞洲(香港)有限公司 is wholly owned by Baillie Gifford Overseas Limited and holds a Type 1 and a Type 2 license from the Securities & Futures Commission of Hong Kong to market and distribute Baillie Gifford’s range of collective investment schemes to professional investors in Hong Kong. Baillie Gifford Asia (Hong Kong) Limited
柏基亞洲(香港)有限公司 can be contacted at Suites 2713-2715, Two International Finance Centre, 8 Finance Street, Central, Hong Kong. Telephone +852 3756 5700.
South Korea
Baillie Gifford Overseas Limited is licensed with the Financial Services Commission in South Korea as a cross border Discretionary Investment Manager and Non-discretionary Investment Adviser.
Japan
Mitsubishi UFJ Baillie Gifford Asset Management Limited (‘MUBGAM’) is a joint venture company between Mitsubishi UFJ Trust & Banking Corporation and Baillie Gifford Overseas Limited. MUBGAM is authorised and regulated by the Financial Conduct Authority.
Australia
Baillie Gifford Overseas Limited (ARBN 118 567 178) is registered as a foreign company under the Corporations Act 2001 (Cth) and holds Foreign Australian Financial Services Licence No 528911. This material is provided to you on the basis that you are a “wholesale client” within the meaning of section 761G of the Corporations Act 2001 (Cth) (“Corporations Act”). Please advise Baillie Gifford Overseas Limited immediately if you are not a wholesale client. In no circumstances may this material be made available to a “retail client” within the meaning of section 761G of the Corporations Act.
This material contains general information only. It does not take into account any person’s objectives, financial situation or needs.
South Africa
Baillie Gifford Overseas Limited is registered as a Foreign Financial Services Provider with the Financial Sector Conduct Authority in South Africa.
North America
Baillie Gifford International LLC is wholly owned by Baillie Gifford Overseas Limited; it was formed in Delaware in 2005 and is registered with the SEC. It is the legal entity through which Baillie Gifford Overseas Limited provides client service and marketing functions in North America. Baillie Gifford Overseas Limited is registered with the SEC in the United States of America.
The Manager is not resident in Canada, its head office and principal place of business is in Edinburgh, Scotland. Baillie Gifford Overseas Limited is regulated in Canada as a portfolio manager and exempt market dealer with the Ontario Securities Commission ('OSC'). Its portfolio manager licence is currently passported into Alberta, Quebec, Saskatchewan, Manitoba and Newfoundland & Labrador whereas the exempt market dealer licence is passported across all Canadian provinces and territories. Baillie Gifford International LLC is regulated by the OSC as an exempt market and its licence is passported across all Canadian provinces and territories. Baillie Gifford Investment Management (Europe) Limited (‘BGE’) relies on the International Investment Fund Manager Exemption in the provinces of Ontario and Quebec.
Oman
Baillie Gifford Overseas Limited (“BGO”) neither has a registered business presence nor a representative office in Oman and does not undertake banking business or provide financial services in Oman. Consequently, BGO is not regulated by either the Central Bank of Oman or Oman’s Capital Market Authority. No authorization, licence or approval has been received from the Capital Market Authority of Oman or any other regulatory authority in Oman, to provide such advice or service within Oman. BGO does not solicit business in Oman and does not market, offer, sell or distribute any financial or investment products or services in Oman and no subscription to any securities, products or financial services may or will be consummated within Oman. The recipient of this material represents that it is a financial institution or a sophisticated investor (as described in Article 139 of the Executive Regulations of the Capital Market Law) and that its officers/employees have such experience in business and financial matters that they are capable of evaluating the merits and risks of investments.
Qatar
The materials contained herein are not intended to constitute an offer or provision of investment management, investment and advisory services or other financial services under the laws of Qatar. The services have not been and will not be authorised by the Qatar Financial Markets Authority, the Qatar Financial Centre Regulatory Authority or the Qatar Central Bank in accordance with their regulations or any other regulations in Qatar.
Israel
Baillie Gifford Overseas is not licensed under Israel’s Regulation of Investment Advising, Investment Marketing and Portfolio Management Law, 5755-1995 (the Advice Law) and does not carry insurance pursuant to the Advice Law. This material is only intended for those categories of Israeli residents who are qualified clients listed on the First Addendum to the Advice Law.
Ref:13505 10005176





